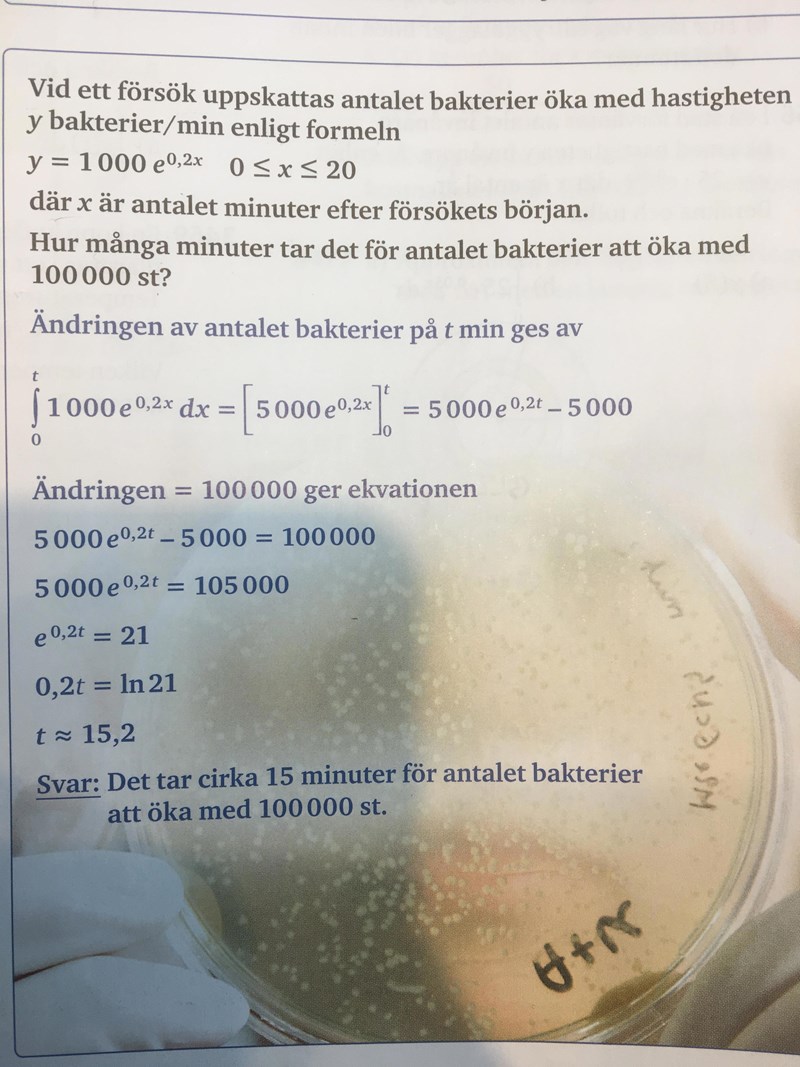

När ska man använda integraler?
Hej ! Den här uppgiften gjorde mig lite osäker på när man använder integraler. Jag tänkte så här:
y= 1000e0,2x = förändringen av antalet bakterier / min , då tänkte jag ställa en ekvation 1000e0,2x = 100000.
Mina frågor är varför blir det fel att lösa ekvationen på det sättet och när ska man använda integraler?
Förändringen är ju derivatan.
Om du tänker dig att förändringen är enklare, tex 10 bakterier per minut, och man frågar efter hur lång tid det (från 0) har blivit 100 bakterier, skulle du med ditt resonemang få ekvationen
10 = 100 (här är ju förändringen konstant och inte beroende av t.
För att få rätt svar måste man ju istället integrera konstanten 10 dvs
10 t = 100
Tusen tack för en bra och snabb svar nu är jag på banan igen.